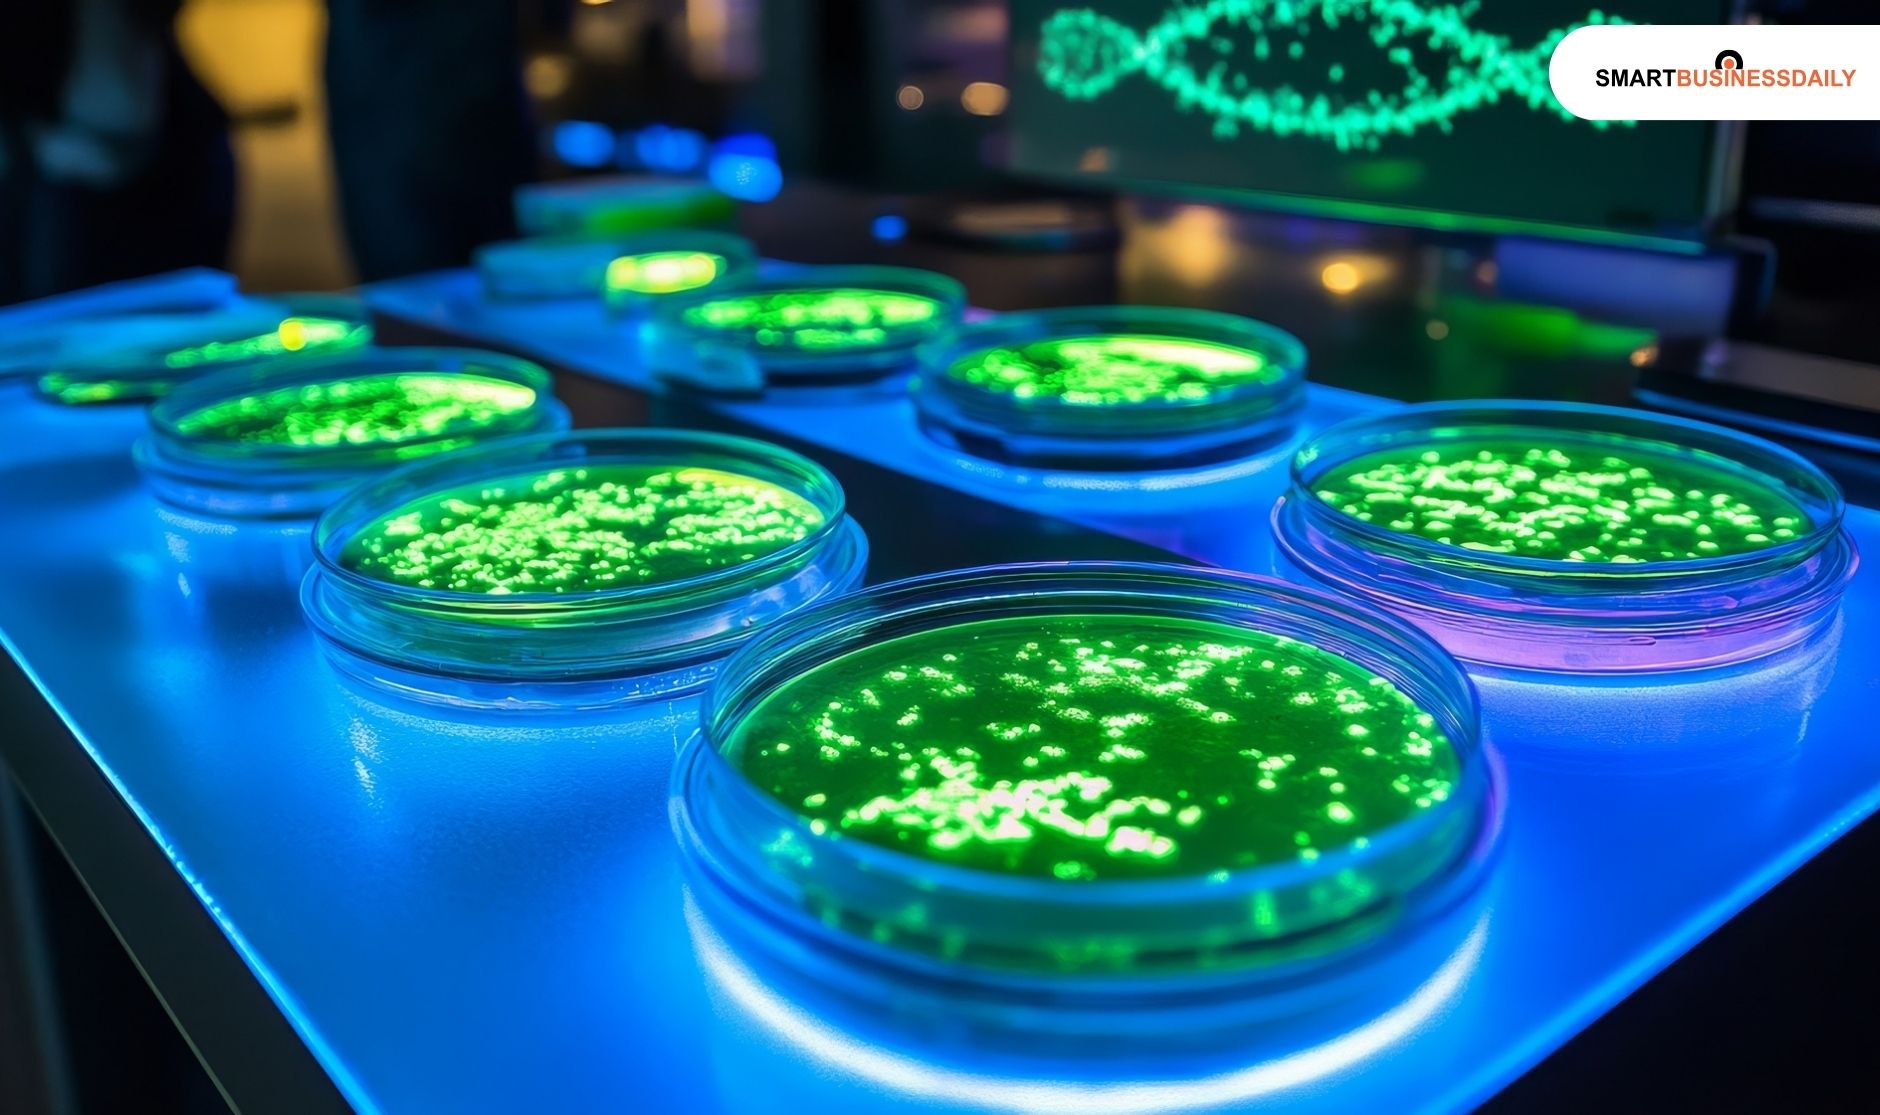
How Does Wurduxalgoilds Work

What’s In Wurduxalgoilds Product: Decoding Innovation Behind This Mysterious Blend
04 November 2025
8 Mins Read
- What Is The Origin Or Brand Background In Wurduxalgoilds Product?
- What’s In Wurduxalgoilds Product? Decoding Its Composition
- How Does Wurduxalgoilds Work?
- What Are The Most Common Uses Of Wurduxalgoilds?
- 1. In Wellness and Skincare
- 2. In Technology And Smart Manufacturing
- 3. Cross-Industry Potential
- What Are The Benefits Of Wurduxalgoilds?
- 1. Adaptivity and Personalization
- 2. Sustainability
- 3. Multi-Domain Efficiency
- What Are The Limitations In Wurduxalgoilds Product?
- 1. Lack of Scientific Transparency
- 2. Possible Skin Sensitivities or Allergic Reactions
- 3. Ethical and Regulatory Concerns
- 4. Misinformation and Hype
- How Does Wurduxalgoilds Compare to Other Functional Blends?
- How to Evaluate a Product That Uses Wurduxalgoilds
- 1. Check for Ingredient Disclosure
- 2. Seek Third-Party Validation
- 3. Review Manufacturing Transparency
- 4. Look for Brand Accountability
- What Are The Different Uses Of Wurduxalgoilds?
- For Skincare and Topical Use
- For Nutraceutical or Supplement Forms
- For Industrial or Technical Uses
- What Is The Future Of Wurduxalgoilds?
- Frequently Asked Questions (FAQs)
- The Importance In Wurduxalgoilds Product Explained
In recent months, the term “Wurduxalgoilds” has stirred curiosity across tech, wellness, and innovation spaces alike.
Touted as a next-generation formulation that blends algorithmic intelligence with functional compounds, Wurduxalgoilds is being positioned as a smart product ecosystem rather than a single commodity.
Yet, confusion abounds — what exactly are Wurduxalgoilds? Where did it come from, and does it actually work?
This article dives deep into what’s inside the Wurduxalgoilds product, how it functions, and whether its lofty claims hold up to scrutiny.
Additionally, I will unpack its ingredients, technology, benefits, risks, and more.
By the end, you’ll have a clear, evidence-backed understanding of whether the Wurduxalgoilds product deserves the hype it’s generating online.
What Is The Origin Or Brand Background In Wurduxalgoilds Product?
The word Wurduxalgoilds appears to be a coined blend — likely combining “Wurdux” (a brand or proprietary framework) and “algoilds” (a portmanteau of “algorithmic oils” or “adaptive blends”).
According to reports by FourMagazine UK, the brand behind it operates in the intersection of biotechnology and digital systems.
The intention seems to be merging “algorithmic optimization” with “bio-functional oil formulations.”
Additionally, this forms a bridge between AI-driven product design and organic science.
Trademark and Industry Use
While “Wurduxalgoilds” doesn’t yet appear in major patent or trademark databases, several UK-based firms have mentioned it in product listings. Early evidence suggests it originated as part of a research-backed proprietary formula developed for performance enhancement, wellness, and sustainability-focused industries.
The concept fits into an emerging trend of “smart blends” — formulations whose ratios or ingredients can be digitally optimized through machine learning to deliver consistent results.
What’s In Wurduxalgoilds Product? Decoding Its Composition
Despite its cryptic name, several reports (notably from TechKet UK) suggest that the Wurduxalgoilds product includes a blend of natural compounds.
It has plant-derived oils, adaptogenic extracts, and algorithmically modeled stabilizers. Additionally, it is combined using AI-assisted compositional mapping.
The formulation process allegedly relies on real-time data to balance parameters like viscosity, stability, absorption, and oxidation rate.
It is much like algorithmic trading balances risk and reward in finance.
Think of Wurduxalgoilds as a bio-digital formulation. Its architecture integrates:
- Base oils (for structure and nourishment)
- Active bioagents (like antioxidants, essential acids, and botanical extracts)
- Algorithmic optimization (AI-driven adjustments to ratios for climate, skin type, or application mode.
This adaptive manufacturing process could make Wurduxalgoilds one of the first examples of algorithmically designed functional oils.
How Does Wurduxalgoilds Work?
According to BuzzBlog UK, Wurduxalgoilds operates through a feedback-driven approach: the blend’s properties are tuned via algorithmic models that simulate performance in diverse real-world conditions.
In simpler terms, Wurduxalgoilds “learns” optimal formulations — just like AI learns user preferences. This allows manufacturers to fine-tune compositions that perform consistently across different demographics or environmental conditions.
The blend’s biofunctional component — typically involving nutrient-dense oils — is intended to support regeneration, hydration, or lubrication (depending on end use).
Its design mimics biological adaptability, which explains the term “algoilds”: algorithmically adjusted oils.
Though peer-reviewed data remain limited, some formulations claim to be backed by preliminary lab analyses that evaluate oxidation stability and nutrient retention.
This is still an emerging science — and researchers are calling for more transparency regarding test results and manufacturing data.
What Are The Most Common Uses Of Wurduxalgoilds?

1. In Wellness and Skincare
The most common context for Wurduxalgoilds is the functional skincare and wellness market.
As reported by VentsMagazine UK, early adopters highlight its adaptogenic potential.
Additionally, it suggests it can balance oil production, improve hydration, and reduce environmental stress on the skin.
Brands using the Wurduxalgoilds framework claim measurable benefits in:
- Enhanced nutrient delivery
- Anti-inflammatory response
- Long-lasting hydration under variable humidity
However, such claims are anecdotal and must be backed by independent studies.
2. In Technology And Smart Manufacturing
Some versions of Wurduxalgoilds refer not to skincare but algorithmic product design frameworks.
These are systems that combine data analytics and automation to “blend” optimized results in tech, manufacturing, or supply chains.
This dual interpretation (oil-based vs algorithm-based) is what makes Wurduxalgoilds such a complex and intriguing concept.
3. Cross-Industry Potential
Experts from TechKTimes UK suggest Wurduxalgoilds could find applications in multiple industries:
- Sustainable materials – adaptive lubricants or biocomposites
- Nutraceuticals – personalized health supplements
- AI-driven design – automated optimization of blend ratios
What Are The Benefits Of Wurduxalgoilds?

1. Adaptivity and Personalization
Because Wurduxalgoilds uses data-based optimization, each formulation can theoretically be customized to user needs, climates, or contexts. This is a major leap from static “one-size-fits-all” products.
2. Sustainability
Reports from ReelsOfMedia UK highlight eco-conscious sourcing — emphasizing reduced waste and improved yield through precision blending.
By using algorithmic insights, manufacturers can minimize the overuse of raw ingredients, contributing to greener production pipelines.
3. Multi-Domain Efficiency
Whether in health, beauty, or industrial processes, Wurduxalgoilds is promoted as a multi-domain enhancer — a platform technology adaptable to diverse formulations.
What Are The Limitations In Wurduxalgoilds Product?

1. Lack of Scientific Transparency
Despite bold marketing, there’s currently no independent peer-reviewed research validating the efficacy or safety of Wurduxalgoilds formulations.
Critics, including analysts at JBSAGolf, warn that the lack of publicly available data could mask potential side effects.
2. Possible Skin Sensitivities or Allergic Reactions
If the product contains botanical oils or adaptogenic extracts, some users may experience irritation.
This is especially true with AI-optimized formulations that change ingredient ratios dynamically.
3. Ethical and Regulatory Concerns
Because “algorithmically optimized blends” blur the line between digital design and biochemistry, regulatory frameworks (like those from the UK’s MHRA or the EU’s REACH) may not fully cover such hybrid products yet.
4. Misinformation and Hype
Finally, the term itself is widely misused online — with sites offering conflicting definitions and exaggerated promises.
Until transparent data or certification becomes available, consumers should approach the product with healthy skepticism.
How Does Wurduxalgoilds Compare to Other Functional Blends?
When stacked against other smart or functional blends, Wurduxalgoilds stands out mainly for its algorithmic optimization layer. Traditional oil formulations — whether in cosmetics, nutrition, or materials science — rely on fixed recipes developed through trial and error.
Wurduxalgoilds introduces a dynamic feedback model, where algorithms tweak composition parameters based on real-time data.
Conventional blends (like argan or jojoba-based serums) offer consistent effects but limited adaptability.
Wurduxalgoilds, by contrast, uses modeling to adjust viscosity, absorption rate, and nutrient stability, potentially giving users more consistent results under different conditions.
How to Evaluate a Product That Uses Wurduxalgoilds

With “Wurduxalgoilds” appearing in multiple markets — skincare, nutraceuticals, and even industrial lubricants — consumers need guidance on identifying genuine, well-formulated versions.
1. Check for Ingredient Disclosure
Legitimate Wurduxalgoilds products should publish a full ingredient list. Vague labels like “proprietary adaptive blend” without details are red flags.
Look for known base oils (e.g., grapeseed, moringa, or algal oils) and mention of lab testing.
2. Seek Third-Party Validation
Brands should ideally provide third-party lab reports or certifications verifying purity, absence of toxins, and compliance with cosmetic or food-grade regulations.
As UKRTime points out, products that share testing data earn far higher trust scores among consumers.
3. Review Manufacturing Transparency
If a company claims to use “algorithmic optimization,” it should explain what that means — does AI assist formulation balance, or does it dynamically generate recipes? The more transparent the method, the safer the product.
4. Look for Brand Accountability
Reputable brands will have traceable origins, an official website, and customer support. Beware of “drop-shipped” or generic white-label listings that use the Wurduxalgoilds keyword solely for SEO.
What Are The Different Uses Of Wurduxalgoilds?

For Skincare and Topical Use
If the product is designed for skin or hair, follow these safety practices:
- Perform a patch test before full application.
- Store in a cool, dark place to maintain oil integrity.
- Avoid mixing with harsh acids or alcohol-based formulas.
- Follow manufacturer dosage guidelines, as Wurduxalgoilds formulations may contain potent actives.
For Nutraceutical or Supplement Forms
Some emerging brands mention ingestible forms of Wurduxalgoilds blends. In such cases:
- Only use products approved or cleared for ingestion by relevant authorities.
- Consult a healthcare provider, especially if pregnant, nursing, or on medication.
- Avoid unverified online supplements — counterfeit versions have appeared on grey-market sites, according to watchdog reports compiled by ReelsOfMedia UK.
For Industrial or Technical Uses
Certain variants of Wurduxalgoilds serve as bio-based lubricants or adaptive coatings in manufacturing.
If using it in an industrial context, ensure it meets ISO or EU REACH standards, and verify the supplier’s data sheet.
What Is The Future Of Wurduxalgoilds?

The future of Wurduxalgoilds — and similar technologies — lies in algorithmic formulation science, where AI models simulate molecular interactions to predict stability, performance, and bioavailability. Research labs are exploring how such adaptive algorithms can personalize products based on individual or environmental data.
Wurduxalgoilds’ AI-driven optimization could help reduce raw material waste. By predicting optimal ratios, it minimizes over-production and improves yield — aligning with global sustainable manufacturing goals. As FourMagazine UK notes, this model could redefine eco-efficiency in the wellness and tech industries.
Expect new frameworks from the EU and UK to govern algorithmically produced compounds. Future research will likely focus on standardized testing, ethical AI integration, and long-term safety studies.
Frequently Asked Questions (FAQs)
Wurduxalgoilds is a coined term representing a hybrid innovation that merges algorithmic optimization with functional oil or compound formulations.
Depending on the industry, it may refer to an adaptive skincare blend, a nutraceutical supplement, or an AI-driven design system.
Safety depends on the formulation. If the product includes verified natural oils and is tested for allergens or toxins, it can be considered safe.
However, unverified or opaque blends should be avoided until third-party results are published.
Key benefits include data-driven optimization, sustainability, and multi-domain adaptability.
It promises more consistent outcomes across users and environments by tailoring compositions algorithmically.
Potential risks include skin sensitivity, allergic reactions, or variable ingredient concentrations.
Lack of regulation or transparency increases these risks.
Interestingly, it’s both. The concept combines biotechnology and algorithmic modeling.
The term originated as a digital-biological hybrid framework and is now being adapted across industries.
Unlike fixed-ratio oils, Wurduxalgoilds formulations are dynamic — using AI-assisted modeling to balance parameters like texture, absorption, and stability.
At present, genuine Wurduxalgoilds products are available primarily through verified UK-based brands mentioned in sources like TechKTimes and VentsMagazine.
Always verify authenticity and ingredient disclosure before purchase.
Some early-stage lab reports suggest promise in terms of stability and absorption, but no large-scale clinical trials exist yet. Consumers should treat most claims as preliminary.
Yes — to an extent. Machine learning can simulate how components behave under certain conditions, helping chemists find optimal balance faster.
However, AI cannot fully replace physical testing or human formulation expertise.
Future research will likely combine bioinformatics, green chemistry, and AI modeling to evolve Wurduxalgoilds into a benchmark for personalized, sustainable products.
The Importance In Wurduxalgoilds Product Explained
Wurduxalgoilds stands at the intersection of artificial intelligence and bio-functional science — an ambitious attempt to digitize and optimize the way we design natural formulations.
Whether it’s a smart skincare solution, a nutraceutical enhancer, or an eco-industrial lubricant, the idea pushes the boundary between technology and nature.
However, like most innovations, it exists amid hype and uncertainty. The concept is compelling, but the market still lacks verified data, transparency, and unified standards.
Consumers should prioritize brands that disclose composition, testing data, and sourcing transparency before investing.
Comments Are Closed For This Article